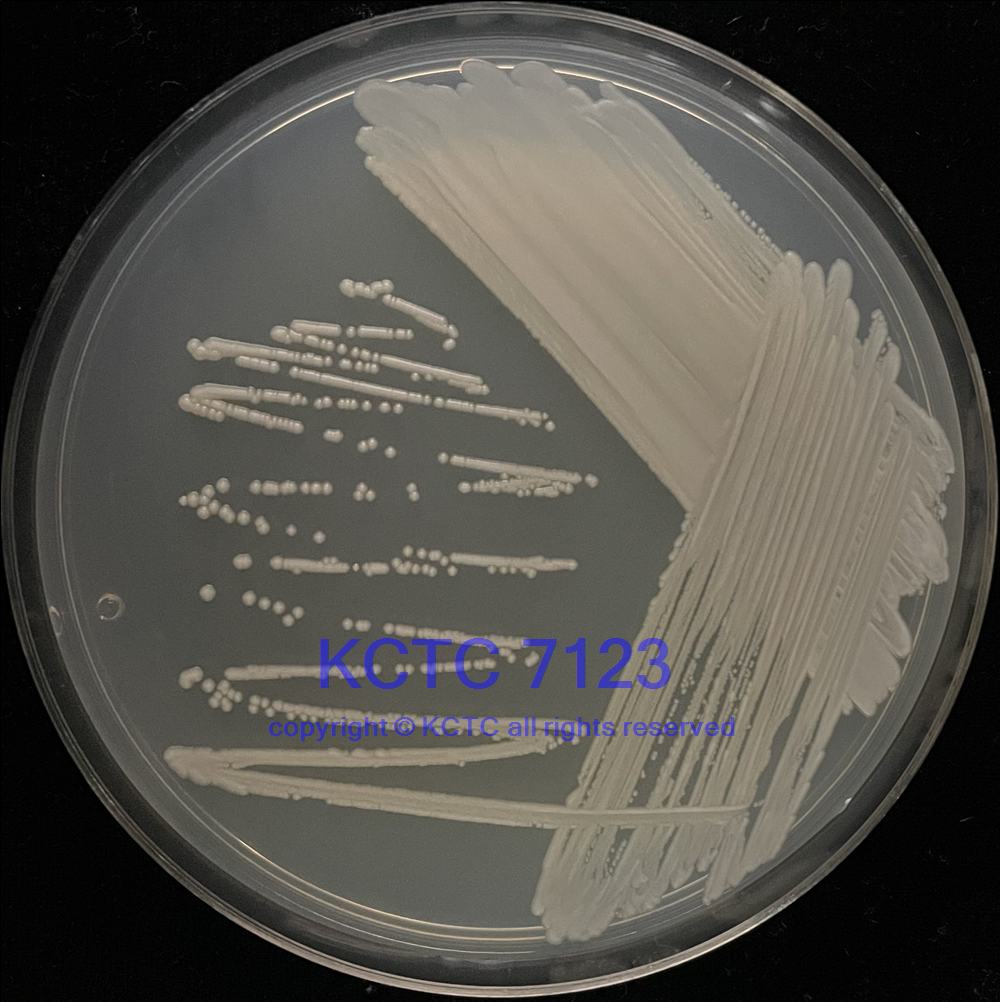

Ogataea polymorpha (Morais et Maia) Yamada, Maeda et Mikata
34438™
DOWNLOAD GENOME
LEARN ABOUT OUR ENHANCED AUTHENTICATION INITIATIVE
An ampoule containing viable cells (may include spores and mycelia) suspended in cryoprotectant.
Product category
Fungi
Product type
Yeast
Strain designation
NRRL Y-5445 [CBS 4732, CCRC 20467, DSM 70277, IFO 1476, JCM 3621, MUCL 27761, NCYC 1457]kctc7123
Type strain
Yes
Genome sequenced strain
Yes
Isolation source
Soil
Geographical isolation
Brazil
Applications
Bioremediation
Biofuel production
Product format
Frozen
Storage conditions
-80°C or colder
General
Specific applications
degrades xylose D-xylose
produces acetone reductase
produces alcohol dehydrogenase
produces alcohol oxidase
produces glycerol 2-dehydrogenase (NADP) dihydroxyacetone reductase
produces single-cell protein SCP
procudes copper-containing amine oxidase
produces SCP from xylose
Potential bioremediation agent: lignin
Preceptrol
No
Characteristics
Comments
catalase activity following growth on methanol
Genome sequencing strain (Genolevures Consortium, France).
Handling information
Medium
ATCC Medium 200: YM agar or YM broth
ATCC Medium 28: Emmons' modification of Sabouraud's agar/broth
ATCC Medium 1245: YEPD
Temperature
24-26°C
Atmosphere
Aerobic
Handling procedure
Frozen ampoules packed in dry ice should either be thawed immediately or stored in liquid nitrogen. If liquid nitrogen storage facilities are not available, frozen ampoules may be stored at or below -70°C for approximately one week. Do not under any circumstance store frozen ampoules at refrigerator freezer temperatures (generally -20°C). Storage of frozen material at this temperature will result in the death of the culture.
To thaw a frozen ampoule, place in a 25°C to 30°C water bath, until just thawed (approximately 5 minutes). Immerse the ampoule just sufficient to cover the frozen material. Do not agitate the ampoule.
Immediately after thawing, wipe down ampoule with 70% ethanol and aseptically transfer 10 µL (or any amount desired up to all) of the content onto a plate or broth with medium recommended.
Incubate the inoculum/strain at the temperature and conditions recommended.
Inspect for growth of the inoculum/strain regularly. The sign of viability is noticeable typically after 1-2 days of incubation. However, the time necessary for significant growth will vary from strain to strain.
Handling notes
Type strain; degrades xylose D-xylose; produces acetone reductase; produces alcohol; dehydrogenase; produces alcohol oxidase; produces glycerol 2-dehydrogenase (NADP) dihydroxyacetone reductase; produces single-cell protein SCP; procudes copper-containing amine oxidase; produces SCP from xylose; related products - genomic DNA (ATCC 34438D-5)
Additional information on this culture is available on the ATCC® web site at www.atcc.org.
Quality control specifications
History
Legal disclaimers
ATCC34438